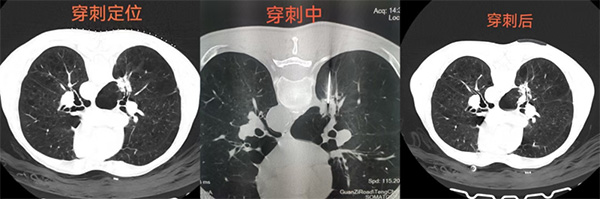
1.jpg

时间:2025-10-14 发布人:小编 浏览:
近日,一名72岁男性患者几经周折后来到我院就诊。患者今年7月初发现双肺结节,曾在省级三甲医院肿瘤外科住院,行纤支镜活检,未取到肿瘤组织无法明确诊断,又到另一家三甲医院诊治无果。经多方打听,了解到我院可以做穿刺活检,为进一步明确肺部占位病变性质,遂到我院诊治。

经增强CT检查发现右肺一病灶特殊,可见分叶、毛刺、胸膜凹陷、充气支气管、棘样突起征,同时病灶周围血管丰富。因患者有重度肺气肿,穿刺活检时发生大出血及气胸等并发症的风险极高。因患者及家属已是几经周折,此次非常期望能够明确诊断。经医学影像科团队反复研究病人情况、病灶特点和周围血管关系后,规划了最优穿刺路径,并制定了大出血及气胸等并发症风险应急预案。充分做好应急处置准备的情况下,在团队成员协助下,熊江主任为患者行经皮肺穿刺活检术,成功获取两条灰褐色、鱼肉样活体肺组织标本送病理科检查。手术过程顺利,15分钟时间完成,未发生任何穿刺并发症。
病检结果提示:(肺结节活检)恶性肿瘤,建议行免疫组化检查进一步诊断。最终明确了病变性质,为患者后续诊疗提供了有力依据。
在肿瘤及疑难疾病诊断中,CT引导下穿刺活检术以其高精度、微创性成为现代医学的“侦察兵”。适用于肺、肝、肾、骨等全身各部位实体病变。该技术通过CT影像引导,精准获取病灶组织,为治疗提供可靠依据。局部麻醉下操作,伤口仅针眼大小,全程约15-20分钟,术后即可活动。

CT引导下穿刺活检术以精准之力,为健康护航!早诊断,早治疗,为生命赢得先机!影像中心将不断运用新理念、开展新技术,助力临床快速诊断、精准治疗,为百姓提供更加优质便捷的健康服务。
医学影像科咨询电话:0875-5160160
下一篇:疼痛怎么办?→来这里看